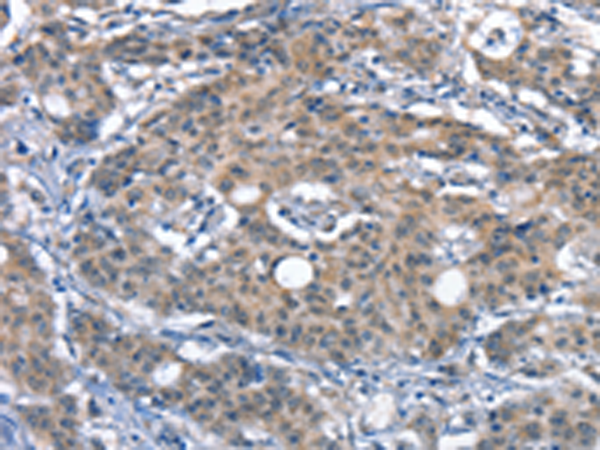

-
分类: 科研抗体货号: P11271别名: SMRT; TRAC; CTG26; SMRTE; TRAC1; N-CoR2; TNRC14; TRAC-1; SMAP270; SMRTE-tau应用: IHC反应种属: Human
-
分类: 科研抗体货号: P11251别名: pf16; Repro-SA-1应用: IHC反应种属: Human, Mouse
-
分类: 科研抗体货号: P11231别名: ACPT; AI1J应用: IHC反应种属: Human, Mouse
-
分类: 科研抗体货号: P11270别名: 2ADUB, 2A-DUB, RP4-592A1.1应用: WB,IHC反应种属: Human, Mouse
-
分类: 科研抗体货号: P11250别名: PTA1; DNAM1; DNAM-1; TLiSA1应用: IHC反应种属: Human
-
分类: 科研抗体货号: P11230别名: C17orf71应用: WB反应种属: Human, Mouse
-
分类: 科研抗体货号: P11269别名: IRF; SMRZ; MURF1; MURF2; RNF28应用: WB,IHC反应种属: Human, Rat
-
分类: 科研抗体货号: P11249别名: CR; C3DR; CD21; CVID7; SLEB9应用: IHC反应种属: Human, Mouse
-
分类: 科研抗体货号: P11229别名: PKX1应用: WB,IHC反应种属: Human
-
分类: 科研抗体货号: P11268别名: DRCC1, MUC-13应用: IHC反应种属: Human

鄂公网安备42018502007531号
鄂公网安备42018502007531号

